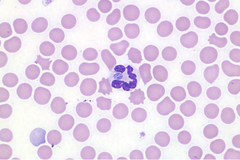

Bệnh lâm sàng và các bất thường về xét nghiệm ở chó bị nhiễm Anaplasma phagocytophiluma
Các dấu hiệu lâm sàng: Sốt, kém ăn, lờ đờ, sưng hạch lâm ba, sưng lách, sưng gan, què, tư thế cứng ngắc, sưng khớp; các dấu hiệu thần kinh và dễ bị chảy máu ít thấy hơn. Ói mửa, tiêu chảy và ho là hiếm.
Các phát hiện trong xét nghiệm: Giảm tiểu cầu máu từ nhẹ đến nặng nề, tăng nhẹ albumin trong máu (hypoalbuminemia), hoạt tính ALP tăng trong huyết thanh, giảm bạch cầu máu, giảm bạch cầu ưa acid trong máu, bệnh ở bạch cầu đơn nhân, đôi khi giảm bạch cầu trung tính trong máu hay tái tạo bạch cầu hướng chuyển trái, thiếu máu không tái tạo với tế bào máu và huyết sắc tố bình thường, viêm đa khớp thấm bạch cầu trung tính (neutrophilic polyarthritis), bệnh ở bạch cầu trung tính chiếm chủ yếu trong dịch não tủy